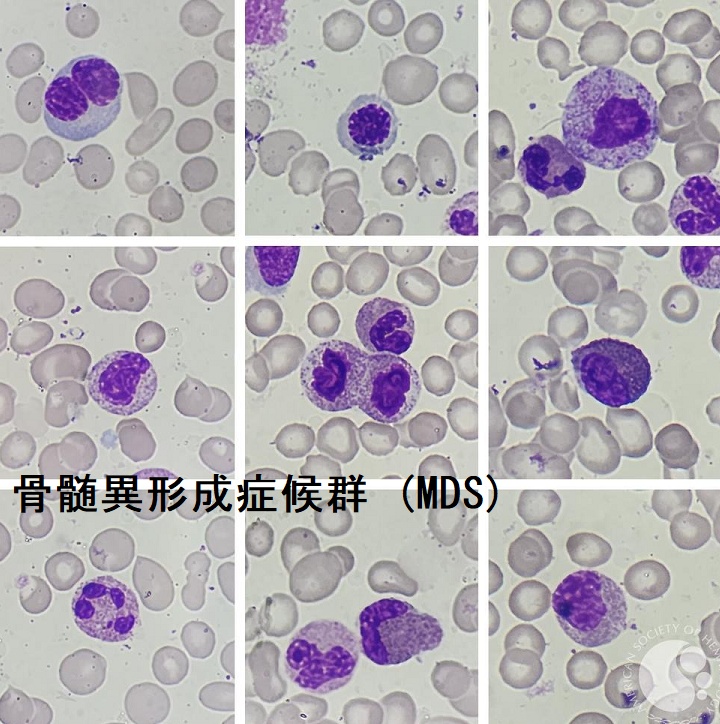

骨髄異形成症候群(MDS)と甲状腺,アザシチジン(ビダーザ®),レナリドマイド[橋本病 バセドウ病 長崎甲状腺クリニック 大阪]
甲状腺:専門の検査/治療/知見③ 橋本病 バセドウ病 甲状腺エコー 長崎甲状腺クリニック大阪
甲状腺専門の長崎甲状腺クリニック(大阪府大阪市東住吉区)院長が海外・国内論文に眼を通して得た知見、院長自身が大阪市立大学附属病院(現、大阪公立大学附属病院) 代謝内分泌内科で得た知識・経験・行った研究、甲状腺学会で入手した知見です。
長崎甲状腺クリニック(大阪)以外の写真・図表はPubMed等において学術目的で使用可能なもの(Creative Commons License)、public health目的で官公庁・非営利団体等が公表したものを一部改変しています。引用元に感謝いたします。尚、本ページは長崎甲状腺クリニック(大阪)の経費で非営利的に運営されており、広告収入は一切得ておりません。
甲状腺・動脈硬化・内分泌代謝に御用の方は 甲状腺編 動脈硬化編 甲状腺以外のホルモンの病気(副甲状腺/副腎/下垂体/妊娠・不妊など) 糖尿病編 をクリックください。
骨髄異形成症候群(MDS)は、造血幹細胞レベルでの後天的な遺伝子異常が原因。無効造血から汎血球減少症を来すことがあります。遺伝子変異の程度により、急性白血病へ移行することもあります。
[下、アメリカ血液学会HPより改変]
長崎甲状腺クリニック(大阪)は甲状腺専門クリニックです。骨髄異形成症候群(MDS)の診療を行っておりません。
Summary
骨髄異形成症候群(MDS)に対する①アザシチジン(ビダーザ®)投与で橋本病急性増悪②サリドマイド誘導体レブラミド®(レナリドミド)は甲状腺機能低下症、破壊性甲状腺中毒症。自己免疫性甲状腺疾患(甲状腺機能低下症/橋本病、バセドウ病)は骨髄異形成症候群(MDS)発症の危険因子。甲状腺機能亢進症/バセドウ病合併骨髄異形性症候群(MDS)の脆い白血球あるいは造血がメルカゾールの影響を受けやすい。甲状腺分化癌(乳頭癌・濾胞癌)の放射性ヨウ素(I-131)治療後に骨髄異形成症候群(MDS)を発症する相対的リスクは、2年目と3年目に一般人口の3.85倍。
Keywords
甲状腺,橋本病,バセドウ病,乳頭癌,濾胞癌,骨髄異形成症候群,甲状腺機能亢進症,甲状腺機能低下症,アザシチジン,MDS
DNAメチル化阻害薬アザシチジン(ビダーザ®)は、骨髄異形成症候群(MDS)治療剤です。骨髄芽球の増加(10%以上)を伴う骨髄異形成症候群(MDS)高リスク群において、同種造血幹細胞移植を行わない場合、化学療法の第一選択薬になります。
骨髄抑制などの副作用は他剤とほぼ同じですが、血液以外の臓器に対する副作用は軽度とされます。
アザシチジンが原因と考えられる橋本病急性増悪(pHD)の報告があります。アザシチジン投与後2 クール目で手指振戦・頸部痛出現、37.5 度以上の熱発、CRP強陽性、甲状腺中毒症(最初は軽度→中等度)、エコーで両葉に左右対称性の低エコー領域を認め圧痛あるも弾性硬(石様硬ではない)、穿刺細胞診はリンパ球優位の炎症像、抗サイログロブリン抗体(Tg-Ab)強陽性・抗甲状腺ペルオキシダーゼ(TPO)抗体陰性。
プレドニゾロン(PSL)30mg開始し、疼痛は速やかに消失するも、甲状腺の破壊性変化は進行、永続性甲状腺機能低下症になったそうです。(第57回 日本甲状腺学会 P2-057 機能とエコー像を対比追跡したazacitidine 関連橋本病急性増悪疑いの一例)
以上を考察すると、橋本病が元々あって癌性リンパ管炎・急性化膿性甲状腺炎 ・亜急性甲状腺炎(SAT)を合併したか、橋本病急性増悪(pHD)を起こしたか診断に迷うところです。
- CRP強陽性は急性化膿性甲状腺炎が濃厚、亜急性甲状腺炎(SAT)では珍しいが報告例あり。癌性リンパ管炎は中等度陽性が多い。
- 穿刺細胞診は好中球でなくリンパ球優位の炎症像で、癌性リンパ管炎は否定、細菌・真菌(アスペルギルス)鏡検・培養陰性で急性化膿性甲状腺炎は否定的。亜急性甲状腺炎(SAT)なら多核巨細胞・類上皮細胞が出る可能性あり。
- 亜急性甲状腺炎(SAT)の低エコー領域は石様硬で、プレドニゾロン(PSL)30mgなら破壊の進行が止まるはず。弾性硬、プレドニゾロン(PSL)30mgで破壊が止まらないのは矛盾
以上より、橋本病急性増悪(pHD)の診断となりますが、結局は除外診断になり、決め手は2.3.です。
筆者の考え;「アザシチジン(ビダーザ®)自体が原因でなく、崩壊する骨髄異形細胞(癌細胞)から放出されたサイトカインが、甲状腺の自己免疫を強力に誘発した」と思います。
免疫調節剤のサリドマイド誘導体レブラミド®(レナリドミド)は、血管新生抑制・抗TNF作用を有し多発性骨髄腫・骨髄異形性症候群(MDS)に有効です。レブラミド®(レナリドミド)は副作用として5-10%に甲状腺機能低下症を引きおこします[Am J Hematol. 2011 Jun; 86(6):467-70.]。その機序は解明されていません。散発的に破壊性甲状腺中毒症が惹起されることもあります。(免疫調節薬と甲状腺)(第55回 日本甲状腺学会 P2-10-06 骨髄異形成症候群に対するレナリドマイド投与後に破壊性甲状腺中毒症を来した1 例)
ネスプ®(ダルベポエチン アルファ:Darbepoetin Alfa)は元々、腎性貧血の治療薬だが、血清エリスロポエチン濃度<200-500 mIU/mL の低リスクまたは中間-1リスク骨髄異形成症候群(MDS)の貧血にも保険適応があります。[Indian J Hematol Blood Transfus. 2022 Apr;38(2):299-308.]
機序は不明ですが、二次性副甲状腺機能亢進症が0.5%未満又は頻度不明に起こります。
骨髄異形成症候群(MDS)の予後因子は、
- 骨髄中で芽球の占める割合;芽球比率が多いほど急性骨髄性白血病に移行しやすく予後不良
- 染色体異常の種類;予後良好群、中間群、不良群に分類される
- 減少する血球系統数;3系統が減少すると予後不良
甲状腺を含む自己免疫疾患(またはその治療)は骨髄異形成症候群(MDS)発症の危険因子です。骨髄異形成症候群(MDS)の病態生理は骨髄微小環境の障害で、自己免疫疾患による過剰な炎症によって悪化する可能性があります。[Lancet Haematol. 2022 Jul;9(7):e523-e534.]
自己免疫性甲状腺疾患は骨髄異形成症候群(MDS)発症の危険因子であり、骨髄異形成症候群(MDS)において血清FT3、FT4 および甲状腺自己抗体価は有意に高く、血清TSH値は有意に低くなる。[Cancer Causes Control. 2008 May;19(4):371-8.]
骨髄異形成症候群(MDS)患者の28%が自己免疫疾患を有しており、その中で甲状腺機能低下症/橋本病が最も多く44%を占めています。バセドウ病は2%。その他、特発性血小板減少性紫斑病が12%、関節リウマチが10%、乾癬が7%。[Am J Hematol. 2016 May;91(5):E280-3.]
そのため、 FT4 7.9 ng/dL で、本来、メルカゾール30mg(=6錠)使用すべき所、20mg(=4錠)+KI 100mgで安定化させた後、甲状腺全摘手術を施行。
甲状腺全摘手術後も偽ペルゲル核異常は消失しないが、無投薬で白血球数・好中球数は正常化したそうです。
(第53回 日本甲状腺学会 P160 骨髄異形成症候群(MDS)を合併したバセドウ病の治療後に血球減少の改善を認めた一例)
(写真はBlood 2015 126; 277より)
甲状腺機能亢進症/バセドウ病では、過剰な甲状腺ホルモンによる代謝亢進から、白血球の消費・ターンオーバーが亢進します(甲状腺機能亢進症/バセドウ病の白血球減少)。筆者の推測として、骨髄異形成症候群(MDS)の構造的に脆い(もろい)白血球・好中球は壊れやすいため、影響が大きかったのかもしれません。
②他の報告例では、
79 歳の高齢者でFT3 11.7 pg/mL、FT4 4.7 ng/dL 程度でWBC 2400/μL、RBC 276 万/μL、Plt 8.3 万/μLと、甲状腺ホルモンによる代謝亢進と鑑別難。メルカゾール10mg=(5mg)x2錠開始4 日目にWBC1100/μL に低下。原因は不明ですが、骨髄異形性症候群(MDS)の脆い白血球あるいは造血がメルカゾールの影響を受けやすかったと、筆者は考えています。(第56回 日本甲状腺学会 P1-088 メルカゾールで白血球減少増悪来した骨髄異形性症候群合併バセドウ病の1 例)
甲状腺分化癌(乳頭癌・濾胞癌)の放射性ヨウ素(I-131)治療後に骨髄異形成症候群(MDS)を発症する相対的リスクは、2年目と3年目に一般人口の3.85倍(95%信頼区間、1.7-7.6);P=0.0005)。(Leukemia. 2018 Apr;32(4):952-959.)
甲状腺関連の上記以外の検査・治療 長崎甲状腺クリニック(大阪)
- 甲状腺編
- 甲状腺編 part2
- 内分泌代謝(副甲状腺/副腎/下垂体/妊娠・不妊等
も御覧ください
長崎甲状腺クリニック(大阪)とは
長崎甲状腺クリニック(大阪)は日本甲状腺学会認定 甲状腺専門医[橋本病,バセドウ病,甲状腺超音波(エコー)検査など]による甲状腺専門クリニック。大阪府大阪市東住吉区にあります。平野区,住吉区,阿倍野区,住之江区,松原市,堺市,羽曳野市,八尾市,東大阪市,天王寺区,生野区も近く。